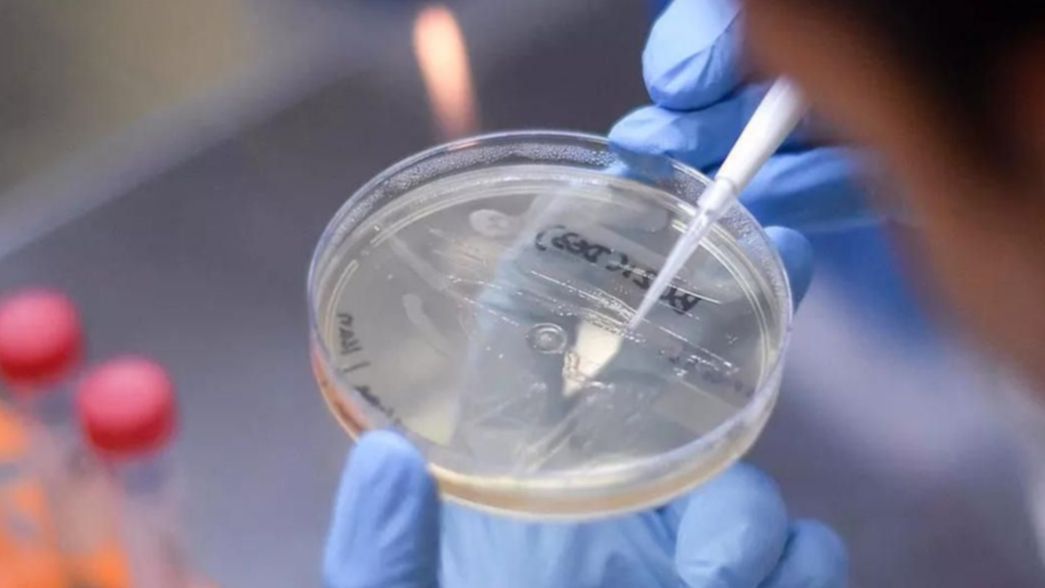
Los contagios siguen cayendo pero los casos de la cepa Delta se triplicaron el último mes

COVID-19
Los contagios siguen cayendo pero los casos de la cepa Delta se triplicaron el último mes
Clasificada como prioritaria por la Organización Mundial de la Salud (OMS), la cepa se expandió rápidamente por todo el mundo y avanza en el país.